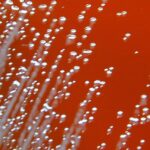

Most of Earth’s species came from explosive bursts of evolution
A new study reveals that the majority of Earth’s species stem from a few evolutionary explosions, where new traits or […]
Most of Earth’s species came from explosive bursts of evolution Read Post »